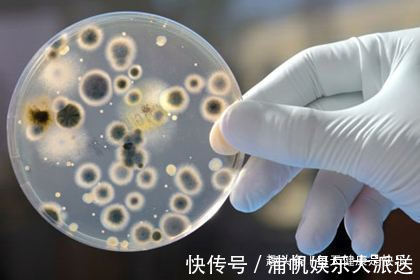
消炎|天然“青霉素”被发现了,没事吃两口,消炎杀菌,提高免疫力

消炎|天然“青霉素”被发现了,没事吃两口,消炎杀菌,提高免疫力
青霉素是我们生活当中比较常见的一种广谱抗生素,有杀菌消炎的作用,当我们身体出现炎症的时候,就可以通过吃青霉素或者是打青霉素的方式来缓解病情,虽然说青霉素的发明给我们带来了很多福音,也帮我们治疗了一些大的疾病,但是万事都有副作用,青霉素也是有一定副作用的,而且很多人还对青霉素过敏。

文章插图
虽然说青霉素的消炎效果很好,但是它总归也属于一种药物,也不能够乱服用,如果服用太多的话,也会损伤我们的肝肾,因此在平时如果身体没有太大问题的话,我们也可以通过吃一些天然的青霉素,在我们生活中,富含天然纤维素的食物也有很多,多吃一些,身体抵抗力也会提高。
文章插图
茴香小茴香是我们生活中比较常见的一位调味料,很多人在包饺子或者是做菜的时候,为了增加香味,通常都会放一些小茴香,因为它独特的味道可以帮我们消灭肠胃当中的一些细菌和病毒,改善一些肠胃疾病,而且平时用小茴香来泡水喝,还能起到清理肠道的作用,对抑制肠道里面的一些细菌幽门螺杆菌也有很好的功效。

文章插图
马齿苋马齿苋在乡间地头是比较常见的一种野菜,马齿苋也被称为天然的青霉素,它能起到清热解毒的功效,而且还能有效缓解肠胃疾病能够促进肠胃的蠕动,预防胃酸的形成,平时多吃一些马齿苋,也能有效降低血压,防止癌细胞入侵。

文章插图
大蒜大蒜里面含有丰富的大蒜辣素,大蒜辣素有消炎杀菌抗病毒的功效,在平时适当吃一些大蒜也能提高我们的免疫力和抵抗力,而且平时适当吃一些大蒜还能有效预防癌细胞的出现,虽然说大蒜的叶味儿比较大,但是平时适当吃一些大蒜,确实能够提高我们的抵抗力,而且还能起到杀菌消炎的功效,它也有天然纤维素之称。

文章插图
如果你平时抵抗力比较低,总是被一些细菌病毒所感染的话,不妨在平时多吃以上这三种食物,没事吃两口抵抗力也会越来越高,更有利于上面身体当中的一些有害菌和细菌。如果你有更多的意见和想法,可以在下方评论区留言补充,小编每天会不定时的推送更多有关健康方面的文章,感谢大家的阅读与支持,若喜欢也可以关注小编的账号,记得给小编点个赞哦!
- 红豆|四九寒天,少吃大鱼大肉,多吃这6种“根菜”,补足营养健康过年
- 免疫|1碗抗癌汤消炎、抗氧化、强免疫!利用大白菜、菇类快速搞定
- 口味|给孩子做个“快手菜” 营养丰富,口味独特,提高身体的免疫力
- 潜伏在我们身边的这3种“致癌”蔬菜,看完你还敢继续吃吗?
- 穆罕默德|伊朗首次通报“奥密克戎”感染者死亡病例
- 鲁南制药集团|菏泽医学专科学校“鲁南制药产业学院”揭牌
- 进行|尿毒症多半是“吃”出来的?3种食物尽量少碰,肾或许“感谢”你
- 苹果是天然润唇膏 你知道吗?
- 生活|提醒:肝病多数是“拖”出来的,出现6种表现,最好查一下肝功
- 羊肉|羊肉到底是“致癌杀手”还是“营养佳品”呢?世卫组织揭晓答案
